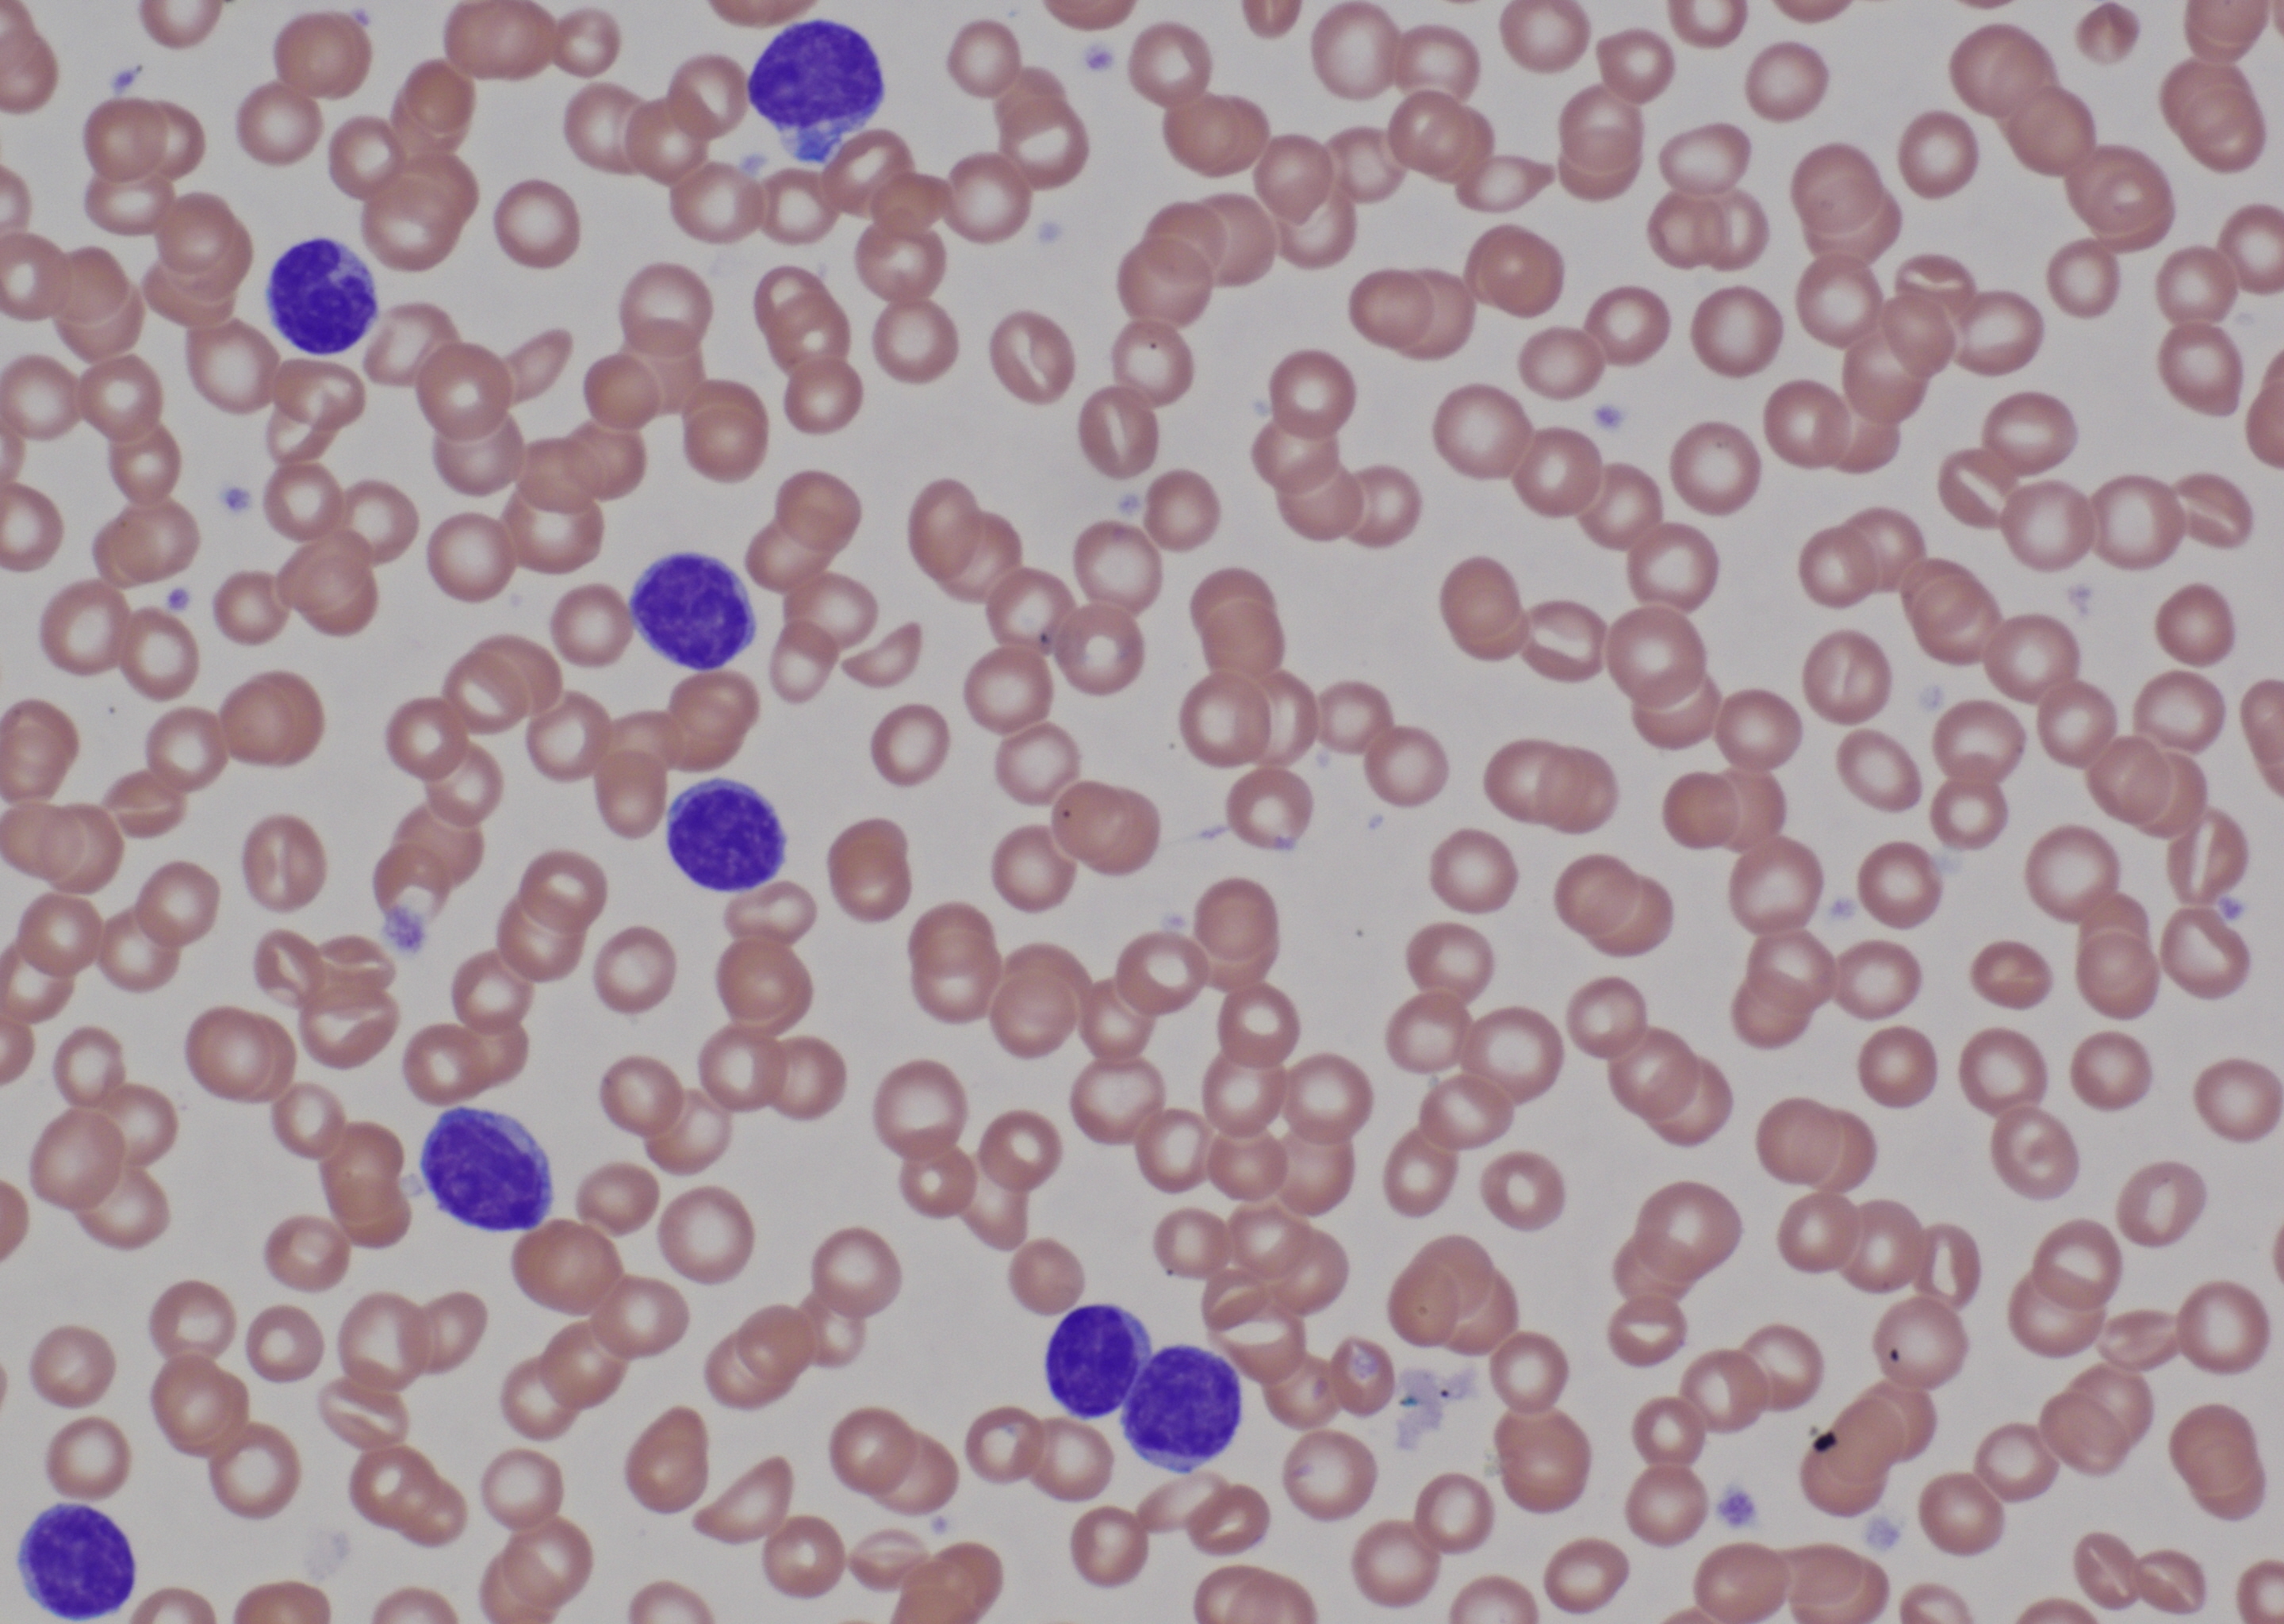

References
Abbas, Syeda Alia, et al. “Direct Coombs Test Positivity in B-Chronic Lymphoid Leukemia: a Marker of Advanced Clinical Disease.” Asian Pacific Journal of Cancer Prevention, vol. 16, no. 14, Feb. 2015, pp. 6007–6010.
Dearden, Claire. “Disease-Specific Complications of Chronic Lymphocytic Leukemia.” Hematology, vol. 2008, no. 1, Jan. 2008, pp. 450–456.
Liu, Huimin, et al. “Prognostic Significance of Serum LDH in B Cell Chronic Lymphoproliferative Disorders: A Single-Institution Study of 829 Cases in China.” Blood, vol. 128, no. 22, Feb. 2016, pp. 5336–5336.
Shaffer, L. G. “A Cytogeneticists Perspective on Genomic Microarrays.” Human Reproduction Update, vol. 10, no. 3, Jan. 2004, pp. 221–226.
Swerdlow, Steven H. WHO Classification of Tumours of Haematopoietic and Lymphoid Tissues. International Agency for Research on Cancer, 2017
Case coordinator: Sertaj Shams
Case reviewer: Dr. Hubert Tsui
Acknowledgements: Dr. Denis Macdonald, Dr. Larissa Liontos, Samira Ahmed
Return to index